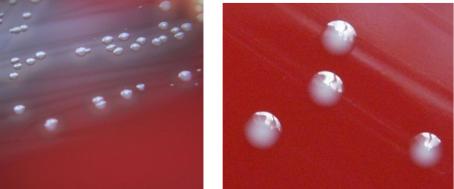
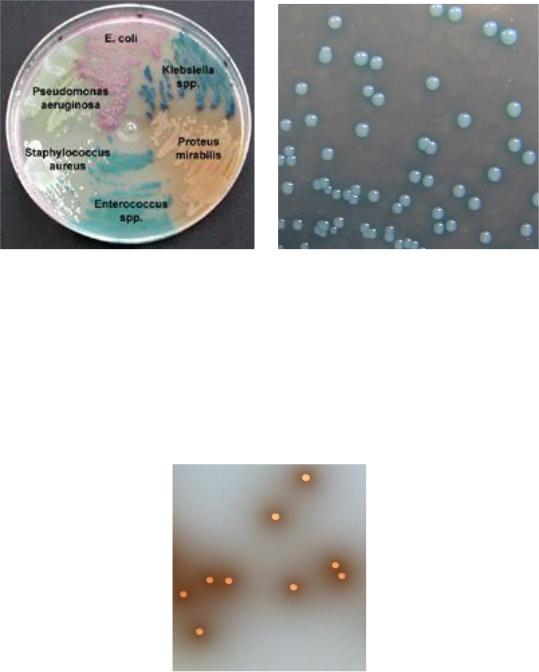

Материал: Грамположительные аэробные Кокки
61
Рисунок 88 – Колонии энтерококков на кровяном агаре.
У энтерококков выражены редуцирующие свойства: они изменяют окраску молока с метиленовым синим. Различные углеводы энтерококки расщепляют до кислоты без газа. Каталазоотрицательные. Все штаммы продуцируют фермент лейцинаминопептидазу (ЛАП).
Энтерококки обладают высокой устойчивостью к различным факторам внешней среды и дезинфицирующим средствам. Они длительное время сохраняются на предметах домашнего обихода, выдерживают нагревание до 60ОС в течение 30 минут.
Факторы патогенности энтерококков. Энтерококки являются представителями нормальной микробиоты желудочно-кишечного тракта, поэтому их можно отнести к условно-патогенным микроорганизмам. Многие факторы, способствующие выживанию энтерококков в определенной экологической нише, можно отнести и к факторам патогенности. Например, адгезины энтерококков участвуют в колонизации слизистых оболочек желудочно-кишечного тракта, а гидролаза желчных кислот позволяет им выживать в двенадцатиперстной кишке.
Гены, кодирующие факторы патогенности, располагаются в особых регионах генома, которые называются островками патогенности (pathogenicity islands, PAI). Энтерококки способны изменять свою вирулентность путем удаления или приобретения отдельных элементов PAI. Островки патогенности являются мобильными элементами и могут передаваться от одного штамма другому. Эта способность позволяет энтерококкам перемещаться в различные биотопы хозяина и вызывать развитие патологического процесса. Для энтерококков характерна природная способность приобретать, аккумулировать и трансформировать экстрахромосомные элементы, кодирующие патогенные свойства.
Основными факторами патогенности энтерококков являются энтерококковый поверхностный белок (Enterococcal surface protein), выполняющий роль адгезина, агрегирующая субстанция, способствующая передаче плазмид, липотейхоевые кислоты, адгезивные молекулы матрикса (MSCRAMM), капсульные полисахариды, гемолизин, желатиназа, гиалуронидаза и другие субстанции (таблица
6).
Таблица 6 – Факторы патогенности энтеробактерий
|
62 |
Название фактора |
Выполняемая функция |
1. Структурные компоненты клетки |
|
1.1. Адгезивные молекулы матрикса |
Адгезия к клеткам макроорганизма, |
(MSCRAMM): |
инвазия |
- энтерококковые поверхностные белки |
|
(Esp, Asa1, EfaA) |
|
- липотейхоевая кислота |
|
1.2. Агрегирующая субстанция (AS) |
Склеивание микробных клеток |
2. Секретируемые компоненты |
|
2.1. Токсины |
|
Цитолизины (CylA, CylM) |
Лизис эукариотических клеток |
2.2. Ферменты агрессии |
|
Желатиназа (GelE) |
Гидролиз желатина и других пептидов |
Гиалуронидаза |
Расщепление гиалуроновой кислоты |
Энтерококковые поверхностные белки (Esp, Asa1, EfaA) участвуют в процессах адгезии и инвазии. Энтерококковый поверхностный белок Esp увеличивает антибиотико-резистентность энтерококков, способствует фиксации бактерий к эпителию мочевого пузыря и формированию биопленок.
Липотейхоевая кислота клеточной стенки индуцирует образование фактора некроза опухоли и интерферона.
Агрегирующая субстанция (AS) является поверхностным белком, способствующим прикреплению микробных клеток к эпителию. У E. faecalis этот белок способствует образованию агрегатов во время конъюгации бактерий, что облегчает обмен плазмидами. В развитии патологического процесса этому белку отводится роль адгезина к клеткам хозяина и белкам внеклеточного матрикса. Кроме того, энтерококки, обладающие AS, более резистентны к фагоцитозу, чем AS-отрицательные штаммы.
Цитолизины (CylA, CylM) поражают эритроциты и некоторые другие эукариотические клетки.
Гемолизин представляет собой белок, способный лизировать эритроциты человека. Гемолитическая активность проявляется четкой зоной гемолиза вокруг колоний на кровяном агаре.
Желатиназа (GelE) гидролизует желатин, коллаген и другие низкомолекулярные пептиды, способствуя инвазии. Желатиназная активность энтерококков проявляется образованием зон опалесценции вокруг колоний на агаре с желатином.
Гиалуронидаза разрушает гиалуроновую кислоту соединительной ткани, что способствует распространению бактерий в организме.
Феромон (FsrB) представляет собой низкомолекулярный пептид, который способствует конъюгационной передаче плазмид между бактериальными клетками. Он также является хемоаттрактантом для нейтрофилов, поэтому участвует в регулировании воспалительной реакции.
Бактериоцины (энтероцины) проявляют литическую активность по отношению к широкому кругу грамположительных и грамотрицательных бактерий: стафилококки, патогенные кишечные палочки, листерии. При контакте с
63
бактериями они способны вызывать повреждение клеточной стенки с последующей гибелью клетки.
Экология энтерококков. Энтерококки являются представителями нормальной микробиоты кишечника, ротовой полости и мочеполовой системы человека. Они играют важную роль в обеспечении колонизационной резистентности слизистых. Основными представителями микробиоты кишечника человека являются E. faecalis (90-95%) и E. faecium (5-10%). Энтерококки обладают выраженной антагонистической активностью в отношении стафилококков и кишечных палочек. Основная причина этого – способность энтерококков продуцировать короткие пептиды – энтероцины. Однако в последние годы возросло количество инфекционных заболеваний человека, вызванных энтерококками. Инфекции, вызываемые энтерококками, носят чаще всего эндогенный характер. Энтерококки вызывают оппортунистические инфекции при значительном снижении резистентности макроорганизма, особенно при травмах кишечника и мочеполового тракта или в результате инструментального обследования. В этих случаях бактерии проникают в стерильные в нормальных условиях органы и ткани и вызывают развитие инфекции.
Энтерококки обладают природной устойчивостью к большинству антибиотиков, особенно к β-лактамным антибиотикам и аминогликозидам. Многие антибиотики действуют на энтерококки бактериостатически. В последние годы появились штаммы энтерококков с высокой вирулентностью, обладающие устойчивостью к ванкомицину (vancomycin-resistant enterococcus, VRE). VRE
способны вызывать внутрибольничные инфекции (инфекции, связанные с оказанием медицинской помощи).
Всанитарной микробиологии энтерококки относятся к группе санитарнопоказательных микроорганизмов.
Эпидемиология и патогенез энтерококковых инфекций. Энтерококки вызывают заболевания у человека только при значительном снижении резистентности организма, при травматизации или инструментальном обследовании кишечника и мочеполового тракта. В этих случаях энтерококки способны вызывать эндокардит, инфекции кожи и мягких тканей, инфекции мочевыводящих путей, остеомиелит, септический артрит, бактериемию, сепсис и другие заболевания. Они способны инфицировать ожоговые раны и имплантированные устройства.
Впоследние годы возросла роль энтерококков в развитии внутрибольничных инфекций. При этом все более широкое распространение получают энтерококки, обладающие множественной устойчивостью к антибиотикам (бета-лактамным антибиотикам, аминогликозидам, тетрациклинам, ванкомицину и др.).
Диагностика энтерококковых инфекций. Основной метод диагностики энтерококковых инфекций – бактериологический. Материалом для исследований служит гной, кровь, моча. Исследуемый материал высевают на кровяной агар. Из подозрительных колоний готовят мазки, окрашивают по Граму и микроскопируют. Характерные колонии пересевают на кровяной агар для получения чистой культуры.
Используют также энтерококк-агар, Enterococcus Agar, HiCrome UTI Agar. На чашках с хромогенным агаром (HiCrome UTI Agar) можно одновременно дифференцировать колонии голубовато-зеленого цвета Enterococcus faecalis от
64
пурпурных колоний Escherichia coli, бесцветных колоний Staphylococcus aureus и
мукоидных колоний голубого цвета Klebsiella pneumoniae и др. (рисунок 89).
а б Рисунок 89 – Характер роста на хромогенной среде разных видов бактерий (а) и
Enterococcus faecalis (б).
Чистую культуру энтерококков высевают на желчно-щелочной агар (ЖЩА) или желчно-эскулиновый агар и в молоко с 0,1% раствором метиленового синего. На ЖЩА через сутки проявляется рост в виде круглых блестящих синеватого цвета слегка выпуклых колоний. На желчно-эскулиновом агаре образуются серые колонии, окруженные черным ободком (рисунок 90).
Рисунок 90 – Колонии энтерококков на желчно-эскулиновом агаре.
В пробирках с молоком происходит редукция метиленового синего и изменение цвета среды с голубого на белый (рисунок 91).

65
Рисунок 91 – Редукция метиленового синего в молоке энтерококками.
Способность культуры расти на ЖЩА и редуцировать метиленовый синий в молоке указывает на ее принадлежность к энтерококкам.
Идентификацию энтерококков по биохимическим признакам можно провести с помощью ЭН-КОККУСтеста (рисунок 92). Этот набор позволяет определять 19 видов энтерококков.
Рисунок 92 – Цвет положительных и отрицательных реакций на ЭН-КОККУС-тесте.
Идентификацию видовой принадлежности энтерококков проводят для назначения эффективной антибиотикотерапии или в целях эпидемиологического наблюдения.
Профилактика. Средства специфической профилактики энтерококковых инфекций отсутствуют. Основное внимание должно уделяться соблюдению правил стерилизации и асептики при выполнении медицинских лечебно-диагностических процедур и оперативных вмешательств.
Лечение энтерококковых инфекций осуществляют с помощью антибиотиков с учетом чувствительности выделенного клона к антимикробным препаратам. Чаще всего используют ампициллин, ванкомицин, тетрациклины, хинолоны. Однако с середины 90-х годов ХХ века получили распространение штаммы энтерококка, устойчивые к ванкомицину, что снижает эффективность лечения энтерококковой инфекции.
Вопросы для контроля усвоения материала
1.Таксономическое положение, морфологические, тинкториальные и биохимические свойства стафилококков.
2.Факторы патогенности стафилококков.